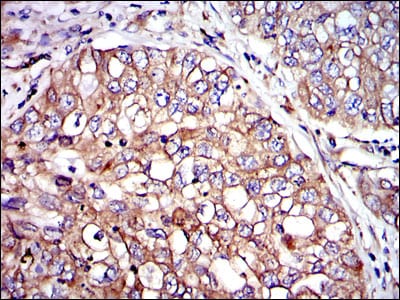

Mouse Monoclonal Antibody to CRK
货号:
30257
别名:
CRKII
应用:
IHC,IF,FCM
反应种属:
Human
抗体类型:
Primary antibody
Swissprot:
P46108
规格:
目录价
在线咨询
Description |
|---|
This gene encodes a member of an adapter protein family that binds to several tyrosine-phosphorylated proteins. The product of this gene has several SH2 and SH3 domains (src-homology domains) and is involved in several signaling pathways, recruiting cytoplasmic proteins in the vicinity of tyrosine kinase through SH2-phosphotyrosine interaction. The N-terminal SH2 domain of this protein functions as a positive regulator of transformation whereas the C-terminal SH3 domain functions as a negative regulator of transformation. Two alternative transcripts encoding different isoforms with distinct biological activity have been described. |
References |
|---|
| 1. Seikagaku. 2009 May;81(5):361-76. 2. Mol Cancer Res. 2009 Sep;7(9):1582-92. |
Specification |
|
|---|---|
| Aliases | CRKII |
| Entrez GeneID | 1398 |
| Swissprot | P46108 |
| clone | 3G11E8 |
| WB Predicted band size | 42kDa |
| Host/Isotype | Mouse IgG2b |
| Antibody Type | Primary antibody |
| Storage | Store at 4°C short term. Aliquot and store at -20°C long term. Avoid freeze/thaw cycles. |
| Species Reactivity | Human |
| Immunogen | Purified recombinant fragment of human CRK expressed in E. Coli. |
| Formulation | Ascitic fluid containing 0.03% sodium azide. |
Application |
|
|---|---|
| IHC | 1/200 - 1/1000 |
| IF | 1/200 - 1/1000 |
| FCM | 1/200 - 1/400 |
| ELISA | 1/10000 |
Product Image
-
Red: Control Antigen (100ng); Purple: Antigen (10ng); Green: Antigen (50ng); Blue: Antigen (100ng);

-
Immunofluorescence analysis of 3T3-L1 cells using CRK mouse mAb (green). Blue: DRAQ5 fluorescent DNA dye. Red: Actin filaments have been labeled with Alexa Fluor-555 phalloidin.

-
Flow cytometric analysis of Hela cells using CRK mouse mAb (blue) and negative control (red).

-
Immunohistochemical analysis of paraffin-embedded human intima cancer tissues using CRK mouse mAb with DAB staining.

-
Immunohistochemical analysis of paraffin-embedded human lung cancer tissues using CRK mouse mAb with DAB staining.

鄂公网安备42018502007531号
鄂公网安备42018502007531号

